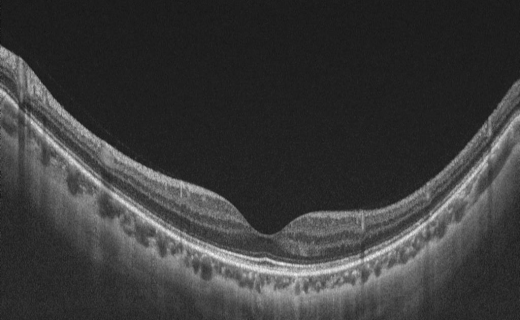
治疗黄斑变性，干湿要分离

放假追剧一时爽,节后返工眼睛干?
来源:
发布时间:2024-02-19

摘镜过新年!屈光手术前要做哪些准备?
来源:
发布时间:2024-02-09

盘点弱视治疗常见误区,值得收藏!
来源:
发布时间:2024-01-31

孩子弱视了怎么办?揭秘弱视的有效治疗方法
来源:
发布时间:2024-01-26

哪些因素会影响弱视治疗效果?
来源:
发布时间:2024-01-12

假如远视储备是货币--用经济学眼光看近视
来源:
发布时间:2024-01-05

孩子弱视会露出四个“破绽”,早点治疗是关键
来源:
发布时间:2023-12-31

弱视的孩子为什么厌学?揭开视力问题背后的心理密码
来源:
发布时间:2023-12-22

弱视的危害这么大,你居然才知道!
来源:
发布时间:2023-12-15

警惕“冷”冬失明!
来源:
发布时间:2023-12-08
治疗黄斑变性,干湿要分离
来源:
发布时间:2023-11-30

甜蜜的“杀手”糖尿病眼病
来源:
发布时间:2023-11-17

警惕!秋季到来,“红眼病”不遥远!
来源:
发布时间:2023-10-27

青光眼患者每天什么时候点眼药水?
来源:
发布时间:2023-10-27

眼药水开封后可以使用多久?
来源:
发布时间:2023-10-12

“防猝死套餐”里的叶黄素到底有啥用?
来源:
发布时间:2023-09-30

游泳虽爽,“红眼病”要当心
来源:
发布时间:2023-09-22

“酱香拿铁”火爆出圈,这些眼病人群莫贪杯
来源:
发布时间:2023-09-08

你知道眼睛里怎么做手术吗?
来源:
发布时间:2023-08-31

儿童斜视手术治疗的几个误区
来源:
发布时间:2023-08-11